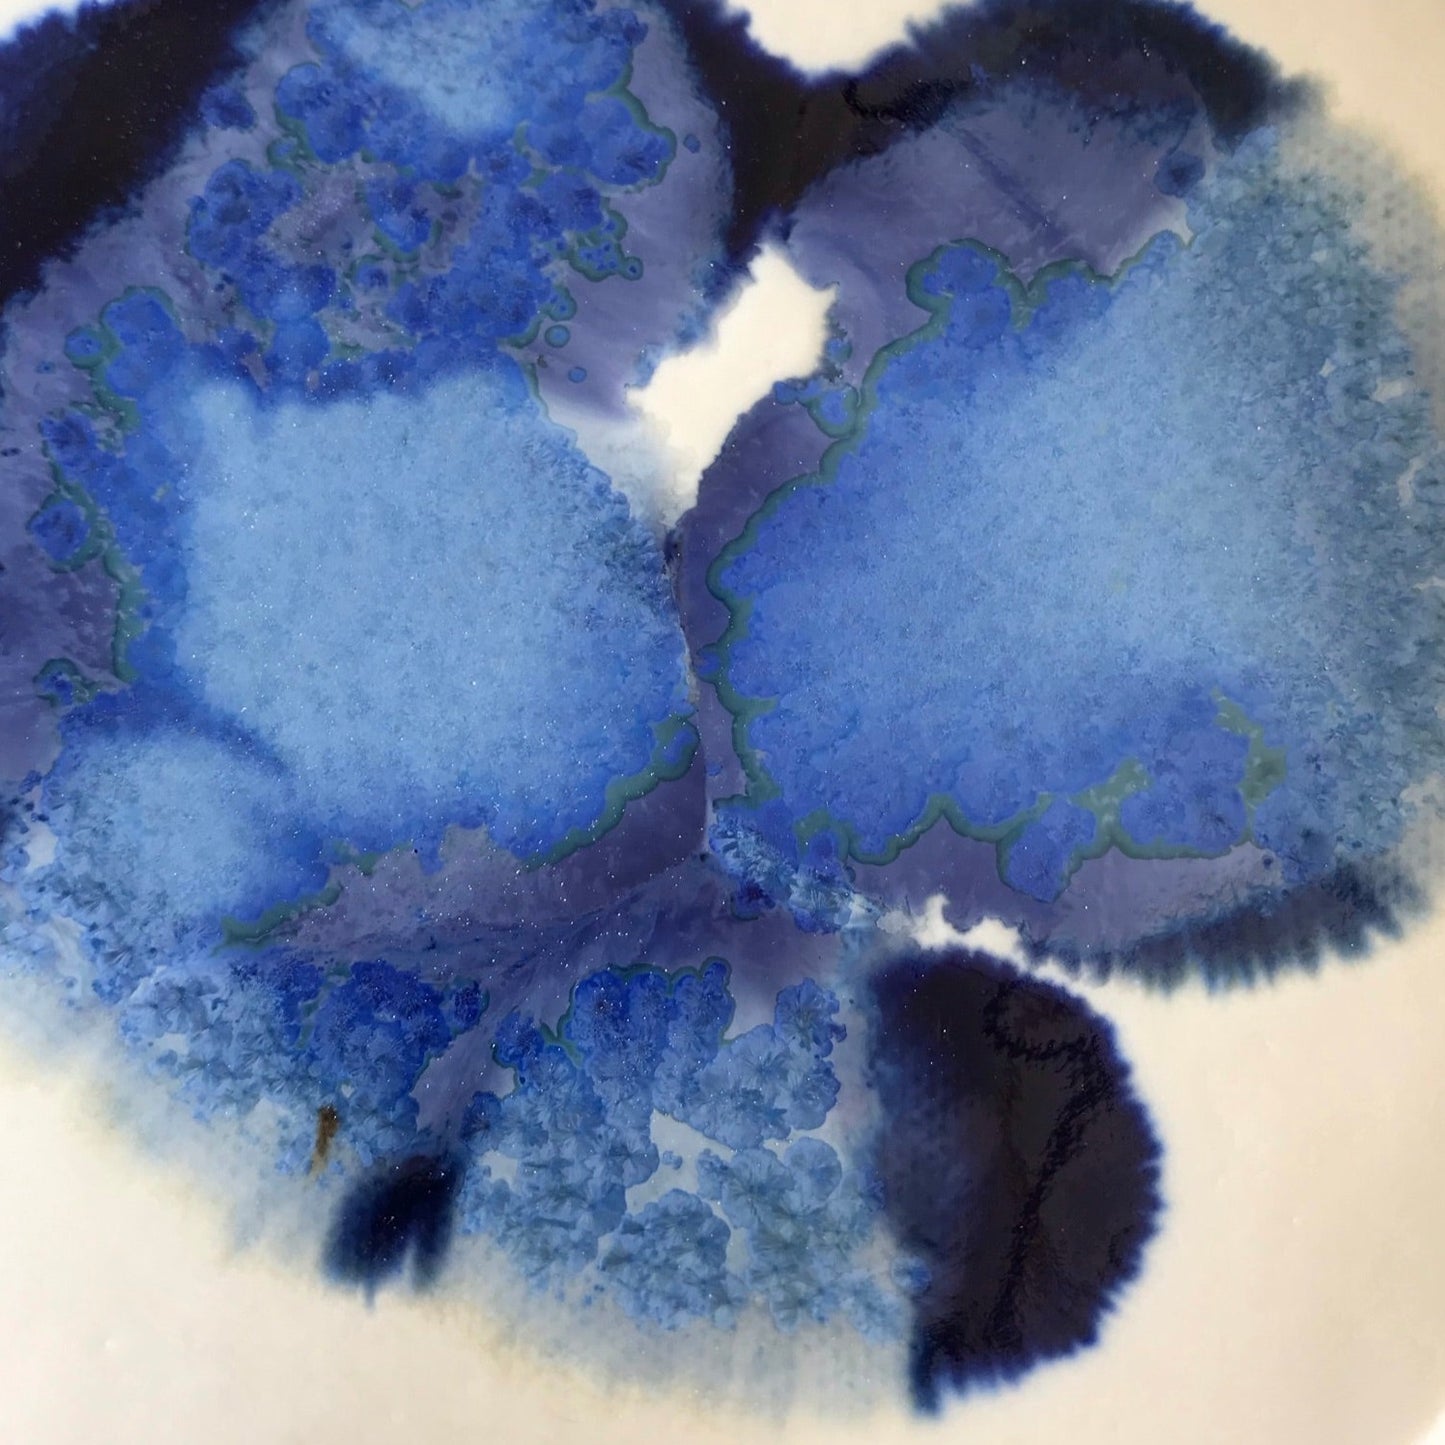

1
/
de
9
Pur Indigo
Assiette à dessert So Blue
Assiette à dessert So Blue
Prix habituel
€15,00 EUR
Prix habituel
Prix promotionnel
€15,00 EUR
Prix unitaire
/
par
Taxes incluses.
Frais d'expédition calculés à l'étape de paiement.
Impossible de charger la disponibilité du service de retrait
Assiette en porcelaine émaillée blanche, motif bleu indigo et bleu glacier.
Motifs tous différents. Forme irrégulière, diamètre 15 cms environ.
Partager